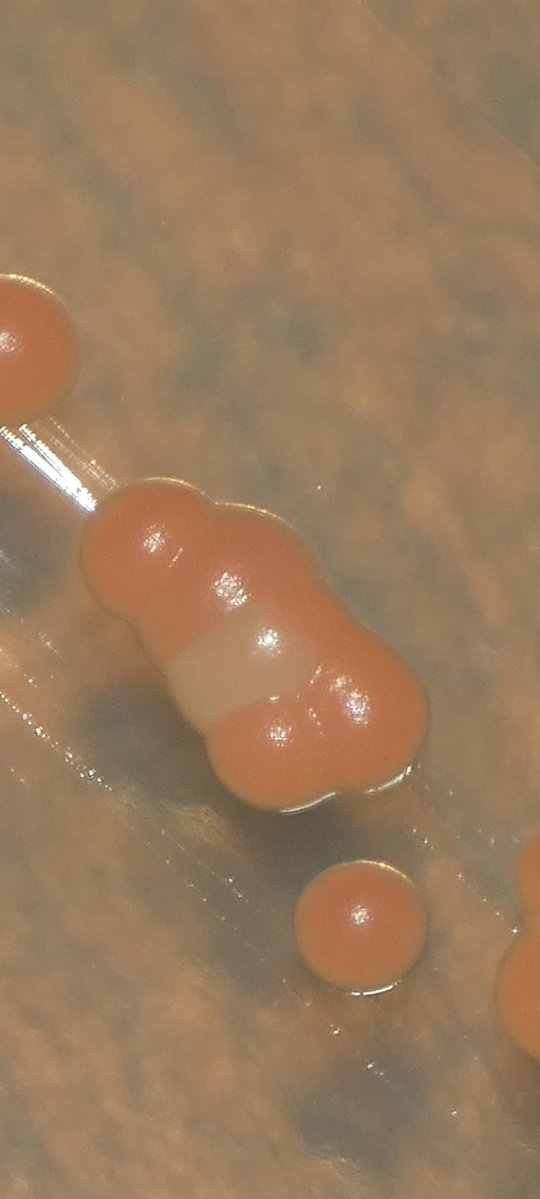
Media 1
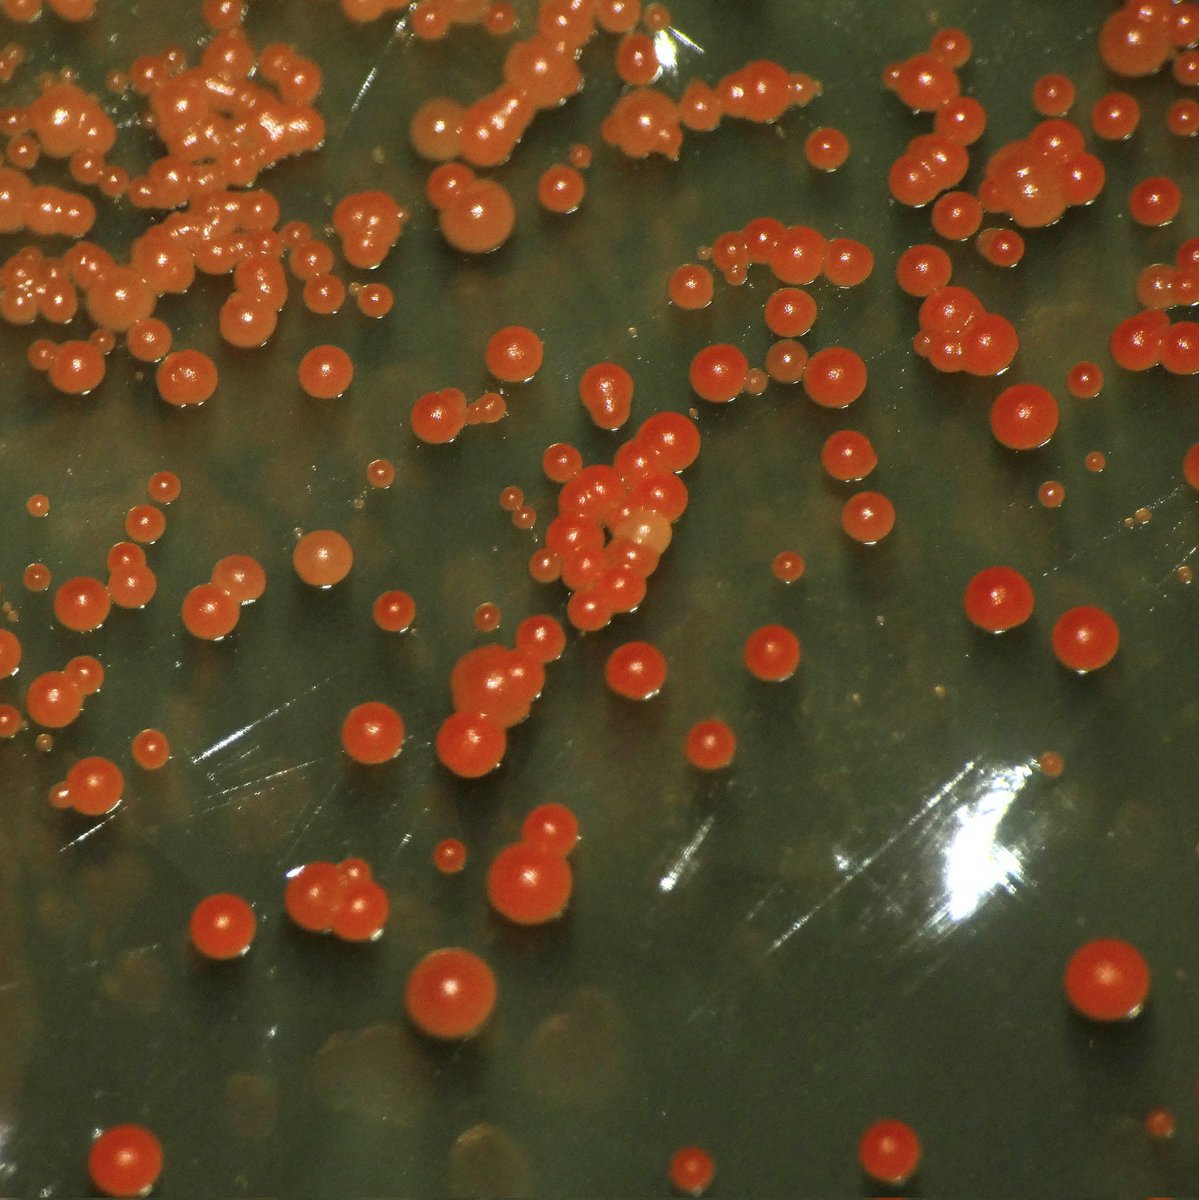
Media 2

Your curated collection of saved posts and media
i 𝐧𝐞𝐞𝐝 𝟏,𝟎𝟎𝟎 𝐡𝐞𝐥𝐥𝐨'𝐬 𝐟𝐫𝐨𝐦 native forever 𝐋𝐨𝐯𝐞𝐫𝐬❤️ https://t.co/EPO9GdJdwG

The makings of what might be @burnaboy’s victory lap album are right in front of us🏆✨https://t.co/yrG7bX6OSl

Drop Like & leave your comments bellow! https://t.co/gi5hJweCsI

Give your voice agents a face. Introducing Lemon Slice-2 – the world's first interactive talking AI video model Think of it as a face layer for your voice agents, available today in production as an API or an embeddable widget. What makes Lemon Slice-2 great: → Easy: All you need is 1 photo → Expressive: hands and full body motion → Any character and style: if it has a face, Lemon Slice-2 can animate it Under the hood: we trained a custom, 20B-parameter video diffusion transformer, streaming at 20fps on a single GPU. Infinite-length video generation with no error accumulation. Talk to the demo avatars on our homepage. Or, add your own interactive avatar to your website. Companies and creators are already building video agents that are: → Customer support agents who screen-share and show you where to click → Lead qualification agents that replace forms with real conversations → AI personal shoppers who try on clothes and guide purchases People don't engage with chat bubbles. They engage with faces. And now you can have a 24/7 spokesperson that’s the face of your brand. We’ve partnered with @elevenlabsio, @trydaily, and @modal to make this happen. As part of this launch, we’re giving away a guide: “How to Add a High-Converting Video Agent to Your Website in under 10 Minutes” Retweet and comment "LEMON SLICE" below and I'll send it over 🍋
🦖: *😴* 🍼: *Getting closer to Phi* 🦖: I’m sleepy… 🍼: Almost fell asleep but woke up again 🍼: You can go back to sleep, go back to sleep The dino sticker is cute 🤏🏻#MaxNat https://t.co/JvZotQDJUO

I think what has become clear over the past year is that the AGI label was never very useful. It is both true that (1) 2025-era Reasoners would meet many prior definitions of AGI & (2) the idea of a single dimensional "intelligence" factor does not help us understand AI impacts https://t.co/3hEkWRMy9x

???????????????????????????????????????????????????????????????? https://t.co/EzvYM7Dw1m


『mebae』さんイラスト「注入!サクラ子さん」 原型制作:ブラウン萬斎 #wf2019w #ネイティブ https://t.co/SUWaPQ5AmT


I don't use Claude's plan mode. I made some potentially uninformed statements today about plan mode, so I learned what it does by looking at the code. This might or might not be useful to you. https://t.co/18u74IrvFH

I've been able to mess with the carotenoid production in this yeast a little by blasting it with UVC light and then growing out the few survivors. Currently trying to isolate some of the palest cultures. Delightfully low-tech way of tweaking an organism 😂🔦⚡ https://t.co/ooeTmsRsDE

Gemini 3 Flash is now available to all Perplexity Pro and Max subscribers. https://t.co/ML3l2fRx3Y

Introducing Scira Voice 🔊 The voice agent for the real-time web. Chat and search the internet or X, hands-free. > Powered by @xAI’s Grok > Supports 100+ languages > Free until Friday Try it here → https://t.co/QWudk6HMrI

⏩ SLIDES just landed on Lovart. One-shot that last-minute presentation. Build your million-dollar pitch deck. Our agent searches the web, reads PDFs, and follows your design instructions. Generate. Play. Edit. Export. This is everything you need. https://t.co/xpjzRn6vcC
BREAKING: Grok Voice Agent ranks #1 in Speech Reasoning Benchmark. https://t.co/6neAVcNOET

#NativeAmerican #native #Gaza #ElonMusk #Springboks https://t.co/kejNcaZELX

#native #NativeAmericanHeritageMonth #NativeAmerican https://t.co/WKGeIIbeFF

#NativeAmerican #native #DWTSFinale #Gaza #motorin #farofadagkay #r4today #AUSvPAK #TECNOAFCON2023 #BlueJays https://t.co/IpiLSdo32i

คือชุบชีวิตไฮเทนชั่นได้ ไม่ธรรมดาน้าคุณน้า https://t.co/FNjDostLJM
more research should be beautiful @physical_int and @thinkymachines have well crafted blogs, who else? https://t.co/OjT3C7sE0R

ขอบคุณที่อดทนรอมานานแสนนานนะคะคุณดีเจงู ไอเริป energy ความอดทนมากกก กราบบบ SOLM IS COMING https://t.co/HN72HCi9hk


Are you ready to Synchronize, anon? Follow us for more #WhitelistGiveaway and #SolanaGiveaways #NFTCommunity #SolanaNFTs #NFTs https://t.co/GcqLrq4Nb3

If you're a Native fan of mine can I get a big….YESS !!! I love you All❤️ https://t.co/z8qZYdACsY
Daily Post Amazing Content 🔥 #Native #nativegirls https://t.co/n810vYnhE7

Please say something about our post or we'll completely disappear from your news feed. Appreciate your help. https://t.co/cXj8tgXuFs

Please say something about this post or we'll completely disappear from your news feed. Appreciate your help. https://t.co/wN8ltzPTbx

TYPE Yes IF YOU SUPPORT NATIVE AMERICAN ✊🇺🇸 https://t.co/80sWEJo596

If you’re a active member of Twitter can I get a big YESS !!!!! I love you All ❤️❤️ https://t.co/bm4CjVLu4X

A journey of a thousand miles begins with a single step https://t.co/lTWxZhhp9A

Applied Research Engineer https://t.co/eQ7e0rIOmg 現在の注力領域として、金融領域や防衛・公共領域へのソリューション開発に取り組んでおり、Applied Research Engineerは最先端の生成AIやAI Agent技術を用いて日本の最重要課題の解決に長期的な視点を持って挑戦します。

Applied Research Engineer https://t.co/eQ7e0rIOmg 現在の注力領域として、金融領域や防衛・公共領域へのソリューション開発に取り組んでおり、Applied Research Engineerは最先端の生成AIやAI Agent技術を用いて日本の最重要課題の解決に長期的な視点を持って挑戦します。

Announcing Arcway ⊹ ࣪ ˖ A real-time 3D engine where anyone can design a home. It is a simulated 3D world where buyers explore, change, and decide as light, physics, building rules, and real products move as one. https://t.co/mt9LhKQQTc
Getting started with @huggingface robot. Are you? https://t.co/gi1bY0df6W
